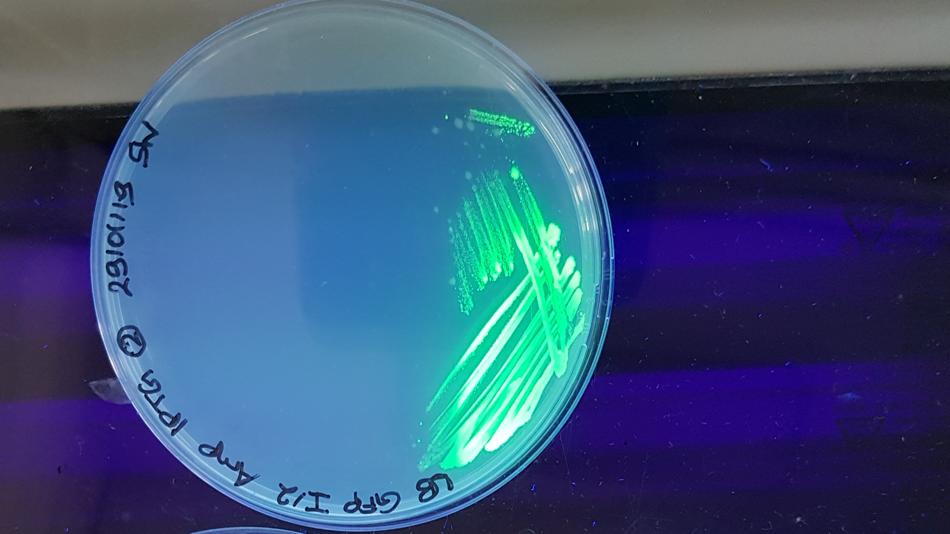
Leuchten durch Biolumineszenz in einer Petrischale dargestellt.

Mitmachstation
Biolumineszenz – Was ist das?
Thema:
Naturwissenschaften
Schlagworte:
Biologie
Altersgruppe:
6 bis 10 Jahre, 10 bis 14 Jahre, 14 bis 18 Jahre und ab 18 Jahre
Zielgruppe:
Barrierefrei
© IMC Krems
In unserer Station zeigen wir, dass sogar Kastanienzweige einen solchen leuchtenden Stoff enthalten, der im Dunkeln sichtbar wird. Außerdem wird über das Grün fluoreszierende Protein (GFP) gesprochen, das aus Quallen stammt und in der Forschung verwendet wird, um Zellen sichtbar zu machen (e.g. E. coli).
Besucherinformation
Dieser Ausstellungsstandort ist barrierefrei zugänglich und verfügt über barrierefreie Toiletten.
IMC Krems
Department of Science and Technology
Institut Biotechnologie
Öffnungszeiten
Erster Einlass: 17:00
Letzter Einlass: 23:00
17 weitere Stationen an diesem Standort
-
 MitmachstationGreenTouch - XR in der Ergotherapie für den ökologischen HandabdruckThema: Digitalisierung UmweltGreenTouch (FFG-gefördert) entwickelt XR (Extended Reality)-Erlebnisse, die zeigen, wie Klimawandel, Gesundheit und Alltag zusammenhängen. In einem ko-kreativen Prozess entwickeln und testen Ergotherapeut:innen und Klient:innen mit dem Forschungsteam Szenarien, bringen ihre Perspektiven ein und entwickeln Lösungsansätze.IMC Krems17:00 - 23:00
MitmachstationGreenTouch - XR in der Ergotherapie für den ökologischen HandabdruckThema: Digitalisierung UmweltGreenTouch (FFG-gefördert) entwickelt XR (Extended Reality)-Erlebnisse, die zeigen, wie Klimawandel, Gesundheit und Alltag zusammenhängen. In einem ko-kreativen Prozess entwickeln und testen Ergotherapeut:innen und Klient:innen mit dem Forschungsteam Szenarien, bringen ihre Perspektiven ein und entwickeln Lösungsansätze.IMC Krems17:00 - 23:00 -
 MitmachstationWelche Betätigungen verrichten wir jeden Tag und wie verändert sich das bei pflegenden Angehörigen?Thema: Gesellschaft GesundheitWas tun wir Tag für Tag und was hält uns im Gleichgewicht? An dieser Station reflektieren Kinder und Erwachsene mit kreativen, spielerischen Impulsen ihre täglichen Aktivitäten und lernen, was Betätigungsbalance bedeutet. Wir zeigen, wie sich die Betätigungsbalance bei pflegenden Angehörigen verändert und eröffnen Gesprächsräume über Wege, den Alltag zu erleichtern und passende Unterstützung zu finden.IMC Krems17:00 - 23:00
MitmachstationWelche Betätigungen verrichten wir jeden Tag und wie verändert sich das bei pflegenden Angehörigen?Thema: Gesellschaft GesundheitWas tun wir Tag für Tag und was hält uns im Gleichgewicht? An dieser Station reflektieren Kinder und Erwachsene mit kreativen, spielerischen Impulsen ihre täglichen Aktivitäten und lernen, was Betätigungsbalance bedeutet. Wir zeigen, wie sich die Betätigungsbalance bei pflegenden Angehörigen verändert und eröffnen Gesprächsräume über Wege, den Alltag zu erleichtern und passende Unterstützung zu finden.IMC Krems17:00 - 23:00 -
 MitmachstationPflege kennen lernen!Thema: GesundheitDas Health Lab öffnet seine Türen: In einem interaktiven Stationenbetrieb können Sie den Alltag auf einer Krankenhausstation selbst erleben. Messen Sie Blutdruck und Temperatur, probieren Sie einfache pflegerische Tätigkeiten aus und erfahren Sie, wie man Pflegeentscheidungen trifft. Mitmachen, erleben, verstehen!IMC Krems17:00 - 23:00
MitmachstationPflege kennen lernen!Thema: GesundheitDas Health Lab öffnet seine Türen: In einem interaktiven Stationenbetrieb können Sie den Alltag auf einer Krankenhausstation selbst erleben. Messen Sie Blutdruck und Temperatur, probieren Sie einfache pflegerische Tätigkeiten aus und erfahren Sie, wie man Pflegeentscheidungen trifft. Mitmachen, erleben, verstehen!IMC Krems17:00 - 23:00 -
MitmachstationPreFOG – Gang im Fokus – Die Möglichkeiten von Ganganalyse und Machine Learning bei ParkinsonThema: Digitalisierung GesundheitAn unserer Station bekommen Sie einen Einblick in den Ablauf und die Grundlagen von KI-basierter Ganganalyse bei Personen mit Parkinson.IMC Krems17:00 - 23:00
-
 MitmachstationTauchen Sie ein in den menschlichen Körper – virtuell und faszinierend!Thema: Digitalisierung GesundheitAn unserem virtuellen Anatomietisch wird der menschliche Körper zum interaktiven Erlebnis. Entdecken Sie Organe, Muskeln und Gefäße in beeindruckender Detailtiefe. Drehen, zoomen und schichten Sie den Körper neu – ganz ohne Skalpell. Forschung zum Anfassen: Erleben Sie Anatomie so realistisch wie nie zuvor und finden Sie heraus, was unter unserer Haut steckt!IMC Krems17:00 - 23:00
MitmachstationTauchen Sie ein in den menschlichen Körper – virtuell und faszinierend!Thema: Digitalisierung GesundheitAn unserem virtuellen Anatomietisch wird der menschliche Körper zum interaktiven Erlebnis. Entdecken Sie Organe, Muskeln und Gefäße in beeindruckender Detailtiefe. Drehen, zoomen und schichten Sie den Körper neu – ganz ohne Skalpell. Forschung zum Anfassen: Erleben Sie Anatomie so realistisch wie nie zuvor und finden Sie heraus, was unter unserer Haut steckt!IMC Krems17:00 - 23:00 -
 MitmachstationEZUS - Echtzeit-Ultraschall in der PhysiotherapieThema: GesundheitEchtzeitultraschall in der Physiotherapie wird eingesetzt, um muskuläre Strukturen, aber auch andere Strukturen, sichtbar zu machen. Dies dient einerseits dazu, dass wir Patient:innen noch gezielter behandeln können und andererseits ist es ein wichtiges Tool, um Dinge besser objektivieren zu können.IMC Krems17:00 - 23:00
MitmachstationEZUS - Echtzeit-Ultraschall in der PhysiotherapieThema: GesundheitEchtzeitultraschall in der Physiotherapie wird eingesetzt, um muskuläre Strukturen, aber auch andere Strukturen, sichtbar zu machen. Dies dient einerseits dazu, dass wir Patient:innen noch gezielter behandeln können und andererseits ist es ein wichtiges Tool, um Dinge besser objektivieren zu können.IMC Krems17:00 - 23:00 -
 VortragDie wunderbare Welt der FarbenThema: NaturwissenschaftenVon antiker Kriegsbemalung bis zur Blue Jeans, von Purpurschnecken bis zur Kaiserkrönung – Farben spielen seit jeher eine zentrale Rolle für die Menschheit.IMC Krems18:00 - 20:45
VortragDie wunderbare Welt der FarbenThema: NaturwissenschaftenVon antiker Kriegsbemalung bis zur Blue Jeans, von Purpurschnecken bis zur Kaiserkrönung – Farben spielen seit jeher eine zentrale Rolle für die Menschheit.IMC Krems18:00 - 20:45 -
 MitmachstationA(C)H! - The Element of SurpriseThema: NaturwissenschaftenDiverse Kleinexperimente zum Ausprobieren und Staunen. Erleben Sie spannende Experimente und spektakuläre Effekte in einer alchimistischen Welt mit Feuer, Rauch und Farben: Entdecken Sie die aufregende Welt der Chemie.IMC Krems17:00 - 23:00
MitmachstationA(C)H! - The Element of SurpriseThema: NaturwissenschaftenDiverse Kleinexperimente zum Ausprobieren und Staunen. Erleben Sie spannende Experimente und spektakuläre Effekte in einer alchimistischen Welt mit Feuer, Rauch und Farben: Entdecken Sie die aufregende Welt der Chemie.IMC Krems17:00 - 23:00 -
 MitmachstationPapierchromatographie von FilzstiftfarbenThema: NaturwissenschaftenDie Farben von Filzstiften sind meistens aus verschiedenen Farbstoffen gemacht. Die Methode, mit der man die einzelnen Farben eines Filzstiftes voneinander trennt, heißt Chromatographie. Bei diesem Experiment kann man herausfinden, aus welchen Grundfarben die Farben in Filzstiften bestehen. Dafür benutzt man Papierchromatographie, weil die Farben unterschiedlich gut in Wasser löslich sind.IMC Krems17:00 - 21:00
MitmachstationPapierchromatographie von FilzstiftfarbenThema: NaturwissenschaftenDie Farben von Filzstiften sind meistens aus verschiedenen Farbstoffen gemacht. Die Methode, mit der man die einzelnen Farben eines Filzstiftes voneinander trennt, heißt Chromatographie. Bei diesem Experiment kann man herausfinden, aus welchen Grundfarben die Farben in Filzstiften bestehen. Dafür benutzt man Papierchromatographie, weil die Farben unterschiedlich gut in Wasser löslich sind.IMC Krems17:00 - 21:00 -
 MitmachstationDNA zum MitnehmenThema: NaturwissenschaftenDNA (Desoxyribonukleinsäure) ist ein Molekül, das in den Zellen aller Lebewesen vorkommt und deren Erbinformationen enthält. Sie ist ein Teil unserer Nahrung.IMC Krems17:00 - 21:00
MitmachstationDNA zum MitnehmenThema: NaturwissenschaftenDNA (Desoxyribonukleinsäure) ist ein Molekül, das in den Zellen aller Lebewesen vorkommt und deren Erbinformationen enthält. Sie ist ein Teil unserer Nahrung.IMC Krems17:00 - 21:00 -
 MitmachstationWie Spenderknochen das Knochenwachstum unterstützenThema: NaturwissenschaftenSpenderknochen (Allografts) unterstützen die Knochenheilung nicht nur als strukturelles Gerüst, sondern auch durch bioaktive Matrixproteine. In unserem Projekt analysieren wir demineralisierte Allografts mittels massenspektrometrischer Proteomik und prüfen ihre Wirkung in stammzellbasierten Assays. So untersuchen wir, welche extrazellulären Proteine die osteogene Differenzierung und Regeneration fördern.IMC Krems17:00 - 23:00
MitmachstationWie Spenderknochen das Knochenwachstum unterstützenThema: NaturwissenschaftenSpenderknochen (Allografts) unterstützen die Knochenheilung nicht nur als strukturelles Gerüst, sondern auch durch bioaktive Matrixproteine. In unserem Projekt analysieren wir demineralisierte Allografts mittels massenspektrometrischer Proteomik und prüfen ihre Wirkung in stammzellbasierten Assays. So untersuchen wir, welche extrazellulären Proteine die osteogene Differenzierung und Regeneration fördern.IMC Krems17:00 - 23:00 -
 MitmachstationWenn Krebszellen unempfindlich gegen Therapien werdenThema: NaturwissenschaftenWir erforschen die Rolle der Rezeptor-Tyrosinkinase AXL bei Therapieresistenz in malignen Tumoren. Ziel ist es, molekulare Signalwege und zelluläre Anpassungsmechanismen zu identifizieren, die Resistenz fördern. Mithilfe funktioneller und molekularbiologischer Analysen untersuchen wir Ansatzpunkte für kombinatorische Therapiestrategien zur Überwindung therapiebedingter Resistenz.IMC Krems17:00 - 23:00
MitmachstationWenn Krebszellen unempfindlich gegen Therapien werdenThema: NaturwissenschaftenWir erforschen die Rolle der Rezeptor-Tyrosinkinase AXL bei Therapieresistenz in malignen Tumoren. Ziel ist es, molekulare Signalwege und zelluläre Anpassungsmechanismen zu identifizieren, die Resistenz fördern. Mithilfe funktioneller und molekularbiologischer Analysen untersuchen wir Ansatzpunkte für kombinatorische Therapiestrategien zur Überwindung therapiebedingter Resistenz.IMC Krems17:00 - 23:00 -
 VortragForschung national & internationalThema: NaturwissenschaftenUnsere Studierenden führen die Forschungsarbeiten für ihre Bachelor- und Masterarbeiten in Firmen und Forschungseinrichtungen in aller Welt durch. Lassen Sie sich ihre Projekte vorstellen!IMC Krems19:00 - 20:00
VortragForschung national & internationalThema: NaturwissenschaftenUnsere Studierenden führen die Forschungsarbeiten für ihre Bachelor- und Masterarbeiten in Firmen und Forschungseinrichtungen in aller Welt durch. Lassen Sie sich ihre Projekte vorstellen!IMC Krems19:00 - 20:00 -
 MitmachstationMassenspektrometrie kann durch die Analyse von Eiweißen im Blut Krankheiten erkennenThema: NaturwissenschaftenMassenspektrometrie kann mit Hilfe von Magnetfeldern das Gewicht, besser gesagt die Masse, von sehr kleinen Teilchen (Molekülen) mit sehr hoher Genauigkeit messen. Zum Beispiel kann es die Masse eines Moleküls von einem Billionstelgramm, 0,000000000001 Gramm, erfassen.IMC Krems17:00 - 23:00
MitmachstationMassenspektrometrie kann durch die Analyse von Eiweißen im Blut Krankheiten erkennenThema: NaturwissenschaftenMassenspektrometrie kann mit Hilfe von Magnetfeldern das Gewicht, besser gesagt die Masse, von sehr kleinen Teilchen (Molekülen) mit sehr hoher Genauigkeit messen. Zum Beispiel kann es die Masse eines Moleküls von einem Billionstelgramm, 0,000000000001 Gramm, erfassen.IMC Krems17:00 - 23:00 -
 MitmachstationCaptain Health - Wie gut navigieren Sie durch das Gesundheitssystem?Thema: GesellschaftTesten Sie Ihr Wissen an unserer interaktiven Station! Per QR Code beantworten Sie kurze Alltagsfragen rund um Gesundheit und Versorgung. Vor Ort erfahren Sie, wie Sie abgeschnitten haben – und bekommen je nach Ergebnis eine passende Vignette: Explorer, Navigator, Co-Pilot oder Captain Health.IMC Krems17:00 - 23:00
MitmachstationCaptain Health - Wie gut navigieren Sie durch das Gesundheitssystem?Thema: GesellschaftTesten Sie Ihr Wissen an unserer interaktiven Station! Per QR Code beantworten Sie kurze Alltagsfragen rund um Gesundheit und Versorgung. Vor Ort erfahren Sie, wie Sie abgeschnitten haben – und bekommen je nach Ergebnis eine passende Vignette: Explorer, Navigator, Co-Pilot oder Captain Health.IMC Krems17:00 - 23:00 -
 MitmachstationDas Geheimnis vom Natur-UrlaubThema: WirtschaftBei dieser Station entdecken Kinder spielerisch, warum Zeit in der Natur Körper und Seele stärkt. Mit spannenden Rätseln und Mitmach-Elementen erforschen sie, wie frische Luft, Bewegung, Pflanzen und Tiere unser Wohlbefinden fördern. Gemeinsam lüften wir das Geheimnis, warum Natur glücklich, gesund und stark macht!IMC Krems17:00 - 23:00
MitmachstationDas Geheimnis vom Natur-UrlaubThema: WirtschaftBei dieser Station entdecken Kinder spielerisch, warum Zeit in der Natur Körper und Seele stärkt. Mit spannenden Rätseln und Mitmach-Elementen erforschen sie, wie frische Luft, Bewegung, Pflanzen und Tiere unser Wohlbefinden fördern. Gemeinsam lüften wir das Geheimnis, warum Natur glücklich, gesund und stark macht!IMC Krems17:00 - 23:00 -
 MitmachstationMarken - Modelle - Millionen: Wie verdienen Unternehmen Geld?Thema: WirtschaftWer steckt hinter bekannten Marken? Wie wird aus einer Idee ein erfolgreiches Geschäftsmodell? Und was ist eigentlich der Unterschied zwischen Umsatz und Gewinn? Bei unserem interaktiven Mit-Mach-Quiz können Sie Ihr Wissen testen, Start-ups und Unternehmen erkennen und spielerisch entdecken, wie Geld verdient wird. Rätseln, raten, lernen – für Neugierige von jung bis alt!IMC Krems17:00 - 21:00
MitmachstationMarken - Modelle - Millionen: Wie verdienen Unternehmen Geld?Thema: WirtschaftWer steckt hinter bekannten Marken? Wie wird aus einer Idee ein erfolgreiches Geschäftsmodell? Und was ist eigentlich der Unterschied zwischen Umsatz und Gewinn? Bei unserem interaktiven Mit-Mach-Quiz können Sie Ihr Wissen testen, Start-ups und Unternehmen erkennen und spielerisch entdecken, wie Geld verdient wird. Rätseln, raten, lernen – für Neugierige von jung bis alt!IMC Krems17:00 - 21:00


